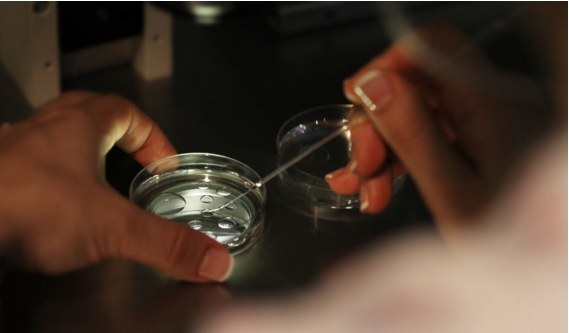

现在国内越来越多医院可以做三代试管婴儿技术了,该技术不但能够解决高龄生育难题,还能实现优生优育,三代试管婴儿技术凭着这一优势,吸引了很多想做第三代试管婴儿的高龄夫妻。
那么问题来了,第三代试管婴儿价格多少钱第三代试管婴儿价格多少钱在做第三代试管费用大概在10-15万元左右,费用主要包含了前期检查费用,药物费用,手术费用,但三代试管婴儿的具体费用是因人而异的,所以上述的数据仅大家了解和参考,具体费用多少还是得根据大家实际的情况来评估。
第三代试管费用主要包含了以下这几个明细:。
1,检查费用夫妻双方做试管婴儿之前,肯定是得先做身体检查的,这些费用至少需要5千元左右。
2,药物费用药物费用主要是由促排卵药物,黄体药物,降调节药物的花费所组成,药物费用会因为每个人的用药方案和个人身体情况而有差异,这些费用至少需要3-10万元左右。
3,手术费用做试管婴儿期间的取卵手术,胚胎移植手术,卵泡浆内单精子显微注射技术,囊胚培养技术,胚胎植入前遗传学检测技术等操作,都是会产生一定的费用的,费用大概在1-5万元左右不等。
虽然现在三代试管婴儿技术很普及,但有些人对该技术不是很了解,尤其是试管的费用问题,那么问题来了,国内做第三代试管婴儿要多少钱国内做第三代试管婴儿要多少钱。
一般国内做一次三代试管婴儿的费用大概在8-10万元左右,大家做试管婴儿的费用主要包括前期准备阶段夫妻双方的化验检查费,卵泡监测费,药物费用,取卵手术费,胚胎培养费和胚胎移植费。
不过,每个人的的实际情况不同,所以做三代试管婴儿的总费用也会有所差别,目前,国内的试管婴儿技术分为一代试管婴儿,二代试管婴儿技术和三代试管婴儿技术,医生会根据患者的实际情况去选择合适的技术,能用简单的办法就决不用复杂的,能用便宜的办法就决不用贵的。
所以大家在做试管婴儿时,不用过于紧张或纠结自己要做哪种试管技术,认真配合医生的治疗即可。
本文由嘉胜国际整理发布,禁止抄袭、复制、转载或引用







